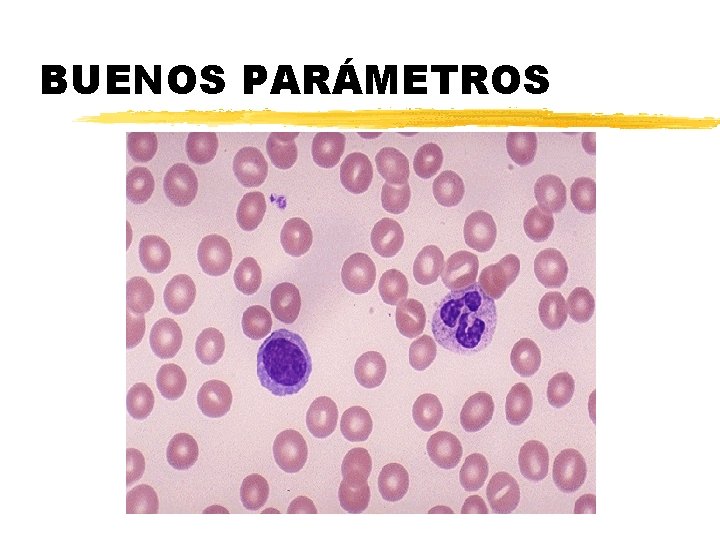
BUENOS PARÁMETROS

EL MICROSCOPIO HISTORIA EL INVENTO z Se invent










































































































- Slides: 106

EL MICROSCOPIO

HISTORIA: EL INVENTO z Se inventó, hacia 1610, por Galileo, según los italianos, o por Jansen, en opinión de los holandeses

EL NOMBRE z. La palabra microscopio fue utilizada por primera vez por los componentes de la "Accademia dei Lincei“ z. Micro=pequeño z. Scopein=ver

GALILEO GALILEI z La “Accademia dei Linceii” era una sociedad científica a la que pertenecía Galileo y publicaron un trabajo sobre la observación microscópica del aspecto de una abeja

MALPIGHI z Las primeras publicaciones importantes aparecen en 1660 y 1665 cuando Malpighi observa los capilares sanguíneos y Hooke publica su obra Micrographia

ANTONY VAN LEENWENHOEK En el siglo XVII un comerciante holandés, utilizando microscopios simples de fabricación propia describió por primera vez protozoos, bacterias, espermatozoides y glóbulos rojos

MICROSCOPIO DE LEEUWENHOEK


CARACTERÍSTICAS DEL MICROSCOPIO DE LEEUWENHOEK z El primitivo microscopio de Leeuwenhoek tenía dos lupas combinadas con las que llegó a alcanzar 260 aumentos, lo cual le permitió visualizar algunos protozoos e infusorios

MICROSCOPIOS DEL SIGLO XVIII

ERNST ABBE z. Las mejoras mas importantes de la óptica surgieron en 1877 cuando Abbe publica su teoría del microscopio

CALR ZEISS z. Mejora la microscopía de inmersión sustituyendo el agua por aceite de cedro lo que permite obtener 2000 aumentos

FUNDAMENTO DE LA MICROSCOPÍA z Cuando el observador se acerca el objeto se agranda z Pero a menos de 25 cm no se ve con claridad z Si se aumenta el ángulo visual se ve con claridad

EVOLUCIÓN DEL MICROSCOPIO

ESQUEMA DEL MICROSCOPIO z Un tubo cilíndrico aloja el sistema óptico ocular/objetivo. Una platina de original diseño permite observar las preparaciones, que son iluminadas por un espejo cóncavo que concentra la luz sobre el objeto a estudiar.

PARÁMETROS ÓPTICOS z. Aumento z. Poder de resolución z. Nº de campo z. Profundidad de foco z. Contraste

AUMENTO z. Se calcula multiplicando el aumento del objetivo por el aumento del ocular

PODER DE RESOLUCIÓN z Distancia si dos puntos se distinguen z Mayor, cuando menor es la longitud de onda z Mayor, cuanto mas grande es la apertura numérica z Mayor, con aceite de cedro

Número de campo z. Es el diámetro de la imagen observada a través del ocular, expresado en milímetros

PROFUNDIDAD DE CAMPO

CONTRASTE z. Diferencia de absorción de luz entre el objeto y el medio z. Puede aumentarse con las tinciones
BUENOS PARÁMETROS

MICROSCOPIO ÓPTICO COMPUESTO

PARTE MECÁNICA QUE SE PUEDE DESMONTAR Estativo Cabezal Tornillos de la platina Oculares Objetivos Condensador

SISTEMA DE SOPORTE O ESTATIVO Tubo Platina Píe Brazo

SISTEMA DE AJUSTE (1) Anillo de ajuste de los oculares Tornillo que permite mover el cabezal Tornillos del condensador Palanca de cierre del diafragma Tornillos reguladores de la platina

SISTEMA DE ENFOQUE Freno Tornillo macrométrico Tornillo micrométrico

PLATINA Pinza Escala

PARTE ÓPTICA z. Sistema de iluminación: fuente de luz, condensador y diafragma z. Lentes: objetivos y oculares

SISTEMA DE ILUMINACIÓN: FUENTE DE LUZ z Suele ser una lámpara halógena de intensidad graduable z Se enciende y apaga con un interruptor z En el exterior puede tener un filtro Filtro Lámpara Interruptor y graduación de la luz

CONDENSADOR Y DIAFRAGMA z Condensador: concentra la luz de la lámpara en un punto de la preparación z Diafragma o iris (está dentro del condensador): si se cierra mejora el contraste, pero empeora la resolución

LENTES: OBJETIVOS z Están colocados en el revolver z Tienen un sistema de amortiguación z Un anillo coloreado indica los aumentos z Son de 4, 10, 40 y 100 (inmersión) aumentos

OBJETIVOS Rojo 4 x Blanco 100 x Amortiguación Amarillo 10 x Azul 40 x

LENTES: OCULARES Ajuste de la distancia interpupilar Oculares

OCULARES: 10 x; 15 x; 20 x

TETRAOCULARES

MATERIAL NECESARIO: PORTAS Y CUBRES

ACEITE DE INMERSIÓN z Hoy no son de madera de cedro, sino sintéticos z Los hay de baja, media y alta viscosidad z Su empleo es imprescindible con el objetivo de inmersión (100 x)

MANEJO DEL MICROSCOPIO z No poner la z Mirando por fuera preparación al revés subir la platina z Regular la luz a z Enfocar y ajustar intensidad media z Pasar al siguiente z Ajustar condensador y aumento y enfocar diafragma al medio z Al acabar retirar la z Empezar poco preparación aumento z Apagar la luz

CONSERVACIÓN DEL MICROSCOPIO z Ponerle su funda al guardarlo z Limpieza de lentes con papel de gafas z El exceso de xilol al limpiar las lentes desgasta el cemento z Usar pincel y pera de aire

TIPOS DE MICROSCOPIOS óptico electrónico Microscopio Óptico Simple Microscopio Óptico Compuesto Lupa M. O. Normal Campo oscuro Contraste de fases Fluorescencia Transmisión Barrido Digital Efecto túnel o cuántico

PODER DE OBSERVACIÓN DEL MICROSCOPIO

MICROSCOPÍA DE CAMPO OSCURO Treponema pallidum

MICROSCOPÍA DE CONTRASTE DE FASES Células epiteliales 20 x

MICROSCOPIA DE FLUORESCENCIA Células epiteliales 200 x

ERNST RUSKA z. El microscopio electrónico de transmisión (T. E. M. ) consiguió aumentos de 100. 000 X. Fue desarrollado por Max Knoll y Ernst Ruska en Alemania en 1931

PRIMER MICROSCOPIO ELECTRONICO z. Utilizó un haz de electrones en lugar de luz para enfocar la muestra. z. Posteriormente, en 1942 se desarrolla el microscopio electrónico de barrido (SEM).

PRIMER M. E. EN ESPAÑA (1949)

MICROSCOPIO ELECTRÓNICO

MICROSCOPIO ELECTRÓNICO DE BARRIDO

M. E. DE TRASMISIÓN Bacilos en división

M. E DE BARRIDO Glóbulo rojo

M. E. DE BARRIDO Glóbulo blanco


Formación imagen microscópica

Formación de la imagen FUENTE DE LUZ Imprescindible para que funcione el microscopio CONDENSADOR Concentra los rayos dispersos e ilumina solo la muestra LENTE OBJETIVO Amplifica la imagen y forma: IMAGEN REAL E INVERTIDA LENTE OCULAR Amplifica la imagen anterior y forma una IMAGEN VIRTUAL LENTE INTRAOCULAR Genera la imagen sobre la retina que es la que el cerebro interpreta

Formación de la imagen en el microscopio OBSERVADOR Objeto 1 Lente Objetivo (converge nte) Imagen en real virtua (Objeto l 2) Lente Ocular (diverge nte)

Poder de resolución z Distancia mínima entre dos objetos para que sean percibidos como objetos separados. z La mayoría de células eucarióticas miden entre 3 y 10 veces menos el poder de resolución del ojo. Poder de resolución Ojo humano Microscopio compuesto 100 mm ó 0. 2 mm ó 200 nm 0. 1 mm Microscopio electrónico 0. 2 nm ó 2 Aº

TEMPORALES FIJAS Muestra +Colorante + Medio de Montaje Muestra + Fijadores + Tinción + Medio de Montaje Cubreobjeto Portaobjeto

Tipos de Microscopios de luz z De campo claro (brillante): el contraste lo provee la tinción de las muestras Imágenes con microscopio de campo claro

Tipos de Microscopios de luz z Contraste de fases: permite observar muestras vivas, o carentes de color Imagen con microscopio de contraste de fases

Tipos de Microscopios de luz z Fluorescente: utiliza luz de longitud de onda corta para excitar los electrones de la muestra Bacillus subtilis esporulando teñidos con FITC, DAPI y βgalactosidasa. Fibroblastos teñidos con el fluorocromo FITC

Tipos de Microscopios de luz z Luz polarizada: utiliza filtros polarizantes para observar estructuras con birrefringencia (emite brillantez) Cristales de ácido urico observados con microscopio de luz polarizada

Tipos de Microscopios de luz z De campo oscuro: para muestras no teñidas, objeto se observa brillante sobre un fondo oscuro Treponema pallidum observado con microscopio de campo oscuro

Tipos de Microscopios de luz z Tridimensional Confocal: utiliza muestras de cortes seriados teñidas con fluorescencia, para reconstruir una imagen tridimensional Secuencias de microscopia confocal

Microscopio confocal

MICROSCOPI A OPTICA CAMPO CLARO Requiere tinciones CONTRASTE DE FASES Permite diferenciar densidades, no tinciones FLUORESCENCIA Utiliza luz UV, usa fluorocromos DE LUZ POLARIZADA Produce birrefringencia CAMPO OSCURO Permite ver muestras vivas, no tinciones CONFOCAL Forma imágenes 3 D

Videomicroscopia digital z Permite el registro y almacenamiento electrónico de imágenes microscópicas poniendo una cámara de vídeo en el plano de la imagen producida por la lente ocular.

Microscopio electrónico z Utiliza electrones en lugar de fotones para formar imágenes de objetos muy pequeños z Funciona con un haz de electrones de alto voltaje z Utiliza lentes magnéticas para formar la imagen sobre una pantalla

Microscopía Electrónica z Aumenta la imagen desde 1000 hasta 250000 veces z Posee mayor poder de resolución que el microscopio óptico, cerca de 2 000 veces. z Existen dos tipos de microscopio electrónico: y. MTE (microscopio de transmisión electrónica) electrones transmitidos a través de una muestra. y. MET (microscopio electrónico tridimensional o de barrido) los electrones rebotan de la superficie de la muestra.


Microscopia electrónica de transmisión Microscopia de un alga roja antes de formar su pared

Microscopia electrónica de barrido Óvulo de hamster sin zona pelucida con espermatozoides Criofractura de epitelio gástrico vista por microscopia de barrido

DE TRANSMISION Permite ver el interior de las estructuras DE BARRIDO Permite ver la superficie de las estructuras MICROSCOPIA ELECTRONICA

Límite de resolución y magnificación Ojo humano Resolución Magnificación 0. 1 mm no produce Microscopio Óptico 200 nm 1000 – 2000 veces Microscopio Electrónico 3 – 5 Aº 250, 000 veces

Microscopía El Microscopio es un instrumento de óptica que permite ver de cerca, y aumentados, objetos pequeños o detalles estructurales imperceptibles a simple vista.

Microscopía óptica(2) Procesado de la muestra biológica para su adecuada observación

Procesamiento de la muestra: • Permitir que la luz la atraviese y podamos observarla • Mantener condiciones cercanas a las naturales Pasos a seguir 1. Obtención de la muestra 2. Fijación 3. Inclusión 4. Corte 5. Tinción 6. Montaje

OBTENCIÓN Ó RECOGIDA DE LA MUESTRA Lo más rápida posible para evitar procesos de descomposición Evitar: Autolisis por liberación de enzimas lisosomales (más rápida) Putrefacción provocada por enzimas bacterianos (más tardía)

FIJACIÓN Evitan la aparición de alteraciones tras la muerte (autolisis y putrefacción) Agentes fijadores • Capacidad fijadora (evitan autolisis) • Capacidad conservante (evitan putrefacción)

TIPOS DE FIJADORES Físicos Congelación: N 2 líquido (-121ºC) Isopentano (-50ºC) Criodesecación o liofilización (desecación por sublimación) Criosustitución (alcohol etílico, acetona o polietilenglicol) Bloqueo de la autolisis. Químicos: desnaturalización o precipitación de proteínas Efecto microbicida. Evitar los efectos osmóticos. Evitar los cambios de textura y composición tisular. Efecto mordiente.

TIPOS DE FIJADORES QUÍMICOS Fijadores por deshidratación tisular (disuelven las grasas): alcohol etílico, metanol, acetona Fijadores por cambio en el estado coloidal de las proteínas (disminución de PH por debajo del PI): ácido acético, ácido tricloroacético y ácido crómico Fijadores que actúan formando sales en los tejidos Fijadores que actúan por reticularización de las proteínas Mezclas fijadoras

INCLUSIÓN Sustancias que producen un endurecimiento de la muestra para su corte adecuado PARAFINA Deshidratación previa mediante fijación en alcohol en gradación ascendente y su Aclarado posterior

CORTE

CORTE

TINCIÓN Según grupos cromóforos: Colorantes básicos: colorean estructuras ácidas Colorantes ácidos: colorean estructuras básicas Colorantes neutros: colorean estructuras diversas Colorantes indiferentes: colorean por impregnación física Colorantes metacromáticos: tiñen de color diferente al del colorante Según criterios de especificidad General Específica: colorean estructuras concretas

TINCIÓN


TINCIÓN GENERAL Y TINCIÓN ESPECÍFICA Tinción Hematoxilina-Eosina

TINCIÓN GENERAL Y TINCIÓN ESPECÍFICA Tinción de Plata. Tejido nervioso

TINCIÓN GENERAL Y TINCIÓN ESPECÍFICA Tinción de Mallory. Colágeno

ALMACENAMIENTO


Preparación y Tinción de las muestras Aunque los microorganismos vivos se pueden examinar directamente con un microorganismos óptico, a menudo hay que fijarnos y teñirlos para aumentar la resolución, acentuar las características morfológicas y conservarlos para su estudio en el futuro.

TINCION SIMPLE Los microorganismos se pueden teñir satisfactoriamente mediante Tinción Simple, esto es, utilizando solo un colorante. El valor de esta clase de tinción radica en su simplicidad y facilidad de empleo. El frotis, previamente fijado, se cubre con un colorante durante el tiempo adecuado, se lava el exceso de colorante con agua y se seca el portaobjetos. Los colorante es básicos como cristal violeta, azul de metileno y carbolfucsina se emplea con frecuencia para determinar el tamaño, la forma y la organización de las bacterias.


TINCION DIFERENCIAL En el primer paso de esta tinción, se tiñe con el colorante básico cristal violeta (violeta de genciana), el colorante primario. A continuación, se trata con una solución yodada que actúa como mordiente. Esto es, el yodo aumenta la interacción entre la célula y el colorante, de forma que aquella se tiñe más intensamente. Luego se decolora el frotis lavándolo con etanol o acetona. Este paso produce el aspecto diferencial de la tinción de Gram; las bacterias Gram positivas retienen el cristal violeta, mientras que las Gram negativas lo pierden y aparecen incoloras. Finalmente, el frotis se tiñe de nuevo con un colorante básico de diferente color al cristal violeta. La safranina es el colorante de contraste más común y tiñen las bacterias Gram negativas de rosa o rojo, dejando a las Gram positivas de color violeta.


La tinción de acido- alcohol resistencia es otro método importante de tinción diferencial. Unas pocas especies, particularmente Mycobacterium no se unen fácilmente a colorantes simples y hay que teñirlas con un tratamiento màs fuerte: calentando una mezcla de fucsina básica y fenol. Una vez que la fucsina básica ha penetrado en la cella con la ayuda del calor y el fenol, las células acido-alcohol resistentes no se decoloran fácilmente con una solución acidoalcohólica, permaneciendo de color rojo. Esto se debe al elevado contenido en lípidos de las paredes de estas células; en partículas, los ácidos micólicos, los responsables de la propiedad de ácido- alcohol resistencia.

Las bacterias no ácido-alcohol resistentes se decoloran con la solución acidoalcoholico, por lo que se tiñen de azul con azul de metileno (tinción de contraste). Este método se emplea para identificar Mycobacterium tuberculosis y M. Leprae. , agente patogenos responsables de la tuberculosis y la lepra.


TINCION DE ESTRUCTURAS ESPECIFICAS Uno de los mas sencillos es la tinción negativa, técnica que revela la presencia de cápsulas difusa alrededor de muchas bacterias. Se mezcla las bacterias con tinta china o colorante de nigrosina y se extienden en una capa fina sobre el portaobjetos. Después de secarlo al aire, las bacterias aparecen como cuerpos más claros en medio de un fondo azul oscuro, porque la tinta y las partículas de colorantes no pueden penetrar ni la célula bacteriana ni su cápsula.

La extensión de la región de luz está determinada por el tamaño de la cápsula y por la propia célula. Apenas se produce modificación de la forma bacteriana y la célula se puede teñir posteriormente para conseguir una mejor visibilidad.

Las bacterias de los géneros Bacillus y Clostridium forman una estructura de supervivencia en condiciones ambientales desfavorables, excepcionalmente resistentes durante periodos largos de tiempo. Esta estructura se denomina endospora pues se desarrolla dentro de la célula. La morfología y la localización de las esdosporas varían con la especie y son a menudo de un gran valor para la identificación bacteriana; pueden ser esféricas a elípticas, con un diámetro menor o superior al de la bacteria madre. Se puede observar con el microscopio de contraste de fases o mediante tinción negativa. Las endosporas no se tiñen bien o mediante tinción negativa. Las endoporas no se tiñen bien con la mayoría de los colorantes, pero una vez teñidos, resisten intensamente la decoloración. Esta propiedad es la base de la mayoría de los métodos de Tinción de endosporas. .

Con el metodo de Schaeffer-Fulton, las endosporas se tiñen primero calentando las bacterias con verde malaquita, la preparación con agua para eliminar el resto de colorante y se contratiñe con safranina. Esta técnica revela endosporas de color rosa a rojo TINCION DE FLAGELOS Los flagelos son estructuras de locomoción en forma de hilo, tan delgados que sólo se pueden observar directamente con el microscopio electrónico. Para observarlos con el M. optico, se aumenta su grosor cubriéndolos con mordientes, como ácido tànico y alumbre de potasio, y tiñéndolos con pararosanilina o fucsina básica. Los métodos de tinción de flagelos ofrecen una información taxonómica importante acerca de su presencia y el modelo de su distribución.
